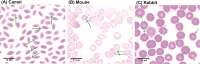
Fig 4

Transmission of 'Candidatus Anaplasma camelii' to mice and rabbits by camel-specific keds, Hippobosca camelina
- PMID: 34398891
- PMCID: PMC8389426
- DOI: 10.1371/journal.pntd.0009671
Transmission of 'Candidatus Anaplasma camelii' to mice and rabbits by camel-specific keds, Hippobosca camelina
Abstract
Anaplasmosis, caused by infection with bacteria of the genus Anaplasma, is an important veterinary and zoonotic disease. Transmission by ticks has been characterized but little is known about non-tick vectors of livestock anaplasmosis. This study investigated the presence of Anaplasma spp. in camels in northern Kenya and whether the hematophagous camel ked, Hippobosca camelina, acts as a vector. Camels (n = 976) and > 10,000 keds were sampled over a three-year study period and the presence of Anaplasma species was determined by PCR-based assays targeting the Anaplasmataceae 16S rRNA gene. Camels were infected by a single species of Anaplasma, 'Candidatus Anaplasma camelii', with infection rates ranging from 63-78% during the dry (September 2017), wet (June-July 2018), and late wet seasons (July-August 2019). 10-29% of camel keds harbored 'Ca. Anaplasma camelii' acquired from infected camels during blood feeding. We determined that Anaplasma-positive camel keds could transmit 'Ca. Anaplasma camelii' to mice and rabbits via blood-feeding. We show competence in pathogen transmission and subsequent infection in mice and rabbits by microscopic observation in blood smears and by PCR. Transmission of 'Ca. Anaplasma camelii' to mice (8-47%) and rabbits (25%) occurred readily after ked bites. Hence, we demonstrate, for the first time, the potential of H. camelina as a vector of anaplasmosis. This key finding provides the rationale for establishing ked control programmes for improvement of livestock and human health.
Conflict of interest statement
The authors have declared that no competing interests exist.
Figures

References
-
- Losos GJ. Infectious tropical diseases of domestic animals. Longman Scientific & Technical;1986.
Publication types
MeSH terms
Grants and funding
LinkOut - more resources
Full Text Sources
Miscellaneous

